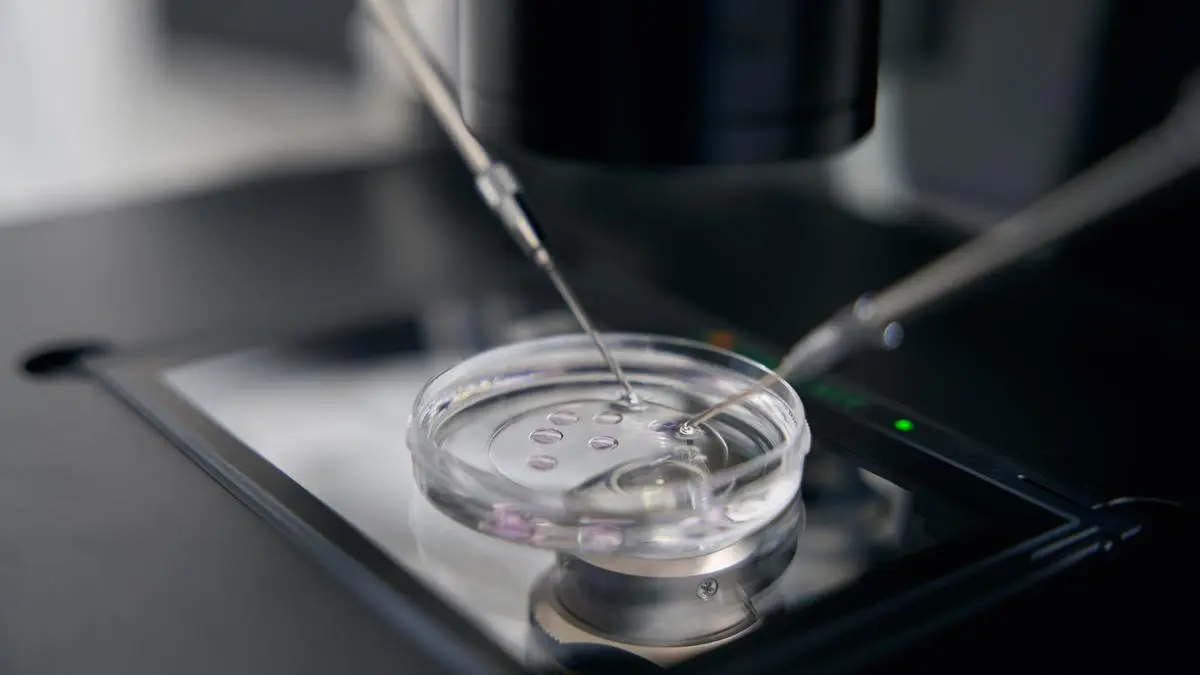

Sie wollen weiterlesen?
Dieser Inhalt ist exklusiv für Digitalabonnent:innen der Kleinen Zeitung.
Leider lassen Ihre derzeitigen Cookie-Einstellungen den Login und damit eine Überprüfung Ihres Abo-Status nicht zu. Eine Darstellung des Inhalts ist dadurch nicht möglich.
Wir verwenden für die Benutzerverwaltung Services unseres Dienstleisters Piano Software Inc. ("Piano"). Dabei kommen Technologien wie Cookies zum Einsatz, die für die Einrichtung, Nutzung und Verwaltung Ihres Benutzerkontos unbedingt notwendig sind. Mit Klick auf "Angemeldet bleiben" aktivieren Sie zu diesem Zweck die Verwendung von Piano und es werden über Ihren Browser Informationen (darunter auch personenbezogene Daten) verarbeitet.
Die Datenschutzinformation von Kleine Zeitung können Sie hier einsehen.